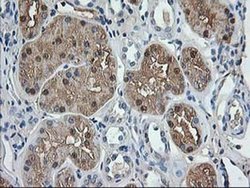
Invitrogen Aminoacylase Monoclonal Antibody (OTI1D4) 100 &mu;L; Unconjugated:Antibodies,

missing translation for 'onlineSavingsMsg'
Learn More
Learn More
Invitrogen™ Aminoacylase Monoclonal Antibody (OTI1D4)


Mouse Monoclonal Antibody
Brand: Invitrogen™ MA525617
This item is not returnable.
View return policy
Description
Aminoacylase Monoclonal Antibody for Western Blot, IHC (P), Flow
ACY1 encodes a cytosolic, homodimeric, zinc-binding enzyme that catalyzes the hydrolysis of acylated L-amino acids to L-amino acids and an acyl group, and has been postulated to function in the catabolism and salvage of acylated amino acids. This gene is located on chromosome 3p21. 1, a region reduced to homozygosity in small-cell lung cancer (SCLC), and its expression has been reported to be reduced or undetectable in SCLC cell lines and tumors. The amino acid sequence of human aminoacylase-1 is highly homologous to the porcine counterpart, and this enzyme is the first member of a new family of zinc-binding enzymes. Mutations in this gene cause aminoacylase-1 deficiency, a metabolic disorder characterized by central nervous system defects and increased urinary excretion of N-acetylated amino acids. Alternative splicing of this gene results in multiple transcript variants. Read-through transcription also exists between this gene and the upstream ABHD14A (abhydrolase domain containing 14A) gene. A related pseudogene has been identified on chromosome 18.
Specifications
| Aminoacylase | |
| Monoclonal | |
| 0.3 mg/mL | |
| PBS with 1% BSA, 50% glycerol and 0.02% sodium azide; pH 7.3 | |
| Q03154, Q99JW2 | |
| ACY1 | |
| Full length human recombinant protein of ACY1 produced in HEK293 cell. | |
| 100 μL | |
| Primary | |
| Human, Mouse | |
| Antibody | |
| IgG1 |
| Flow Cytometry, Immunohistochemistry (Paraffin), Western Blot | |
| OTI1D4 | |
| Unconjugated | |
| ACY1 | |
| 1110014J22Rik; ACY IA; ACY IB; ACY1; ACY-1; Acy1a; ACY-1A; Acy1b; ACY-1B; ACY1D; acylase; aminoacylase 1; aminoacylase I; aminoacylase-1; Aminoacylase-1A; aminoacylase-1B; epididymis secretory protein Li 5; HEL-S-5; N-acylamino acid aminohydrolase (Aminoacylase 1); N-acyl-L-amino-acid amidohydrolase | |
| Mouse | |
| Affinity chromatography | |
| RUO | |
| 109652, 95 | |
| -20°C, Avoid Freeze/Thaw Cycles | |
| Liquid |
Product Content Correction
Your input is important to us. Please complete this form to provide feedback related to the content on this product.
Product Title
Spot an opportunity for improvement?Share a Content Correction